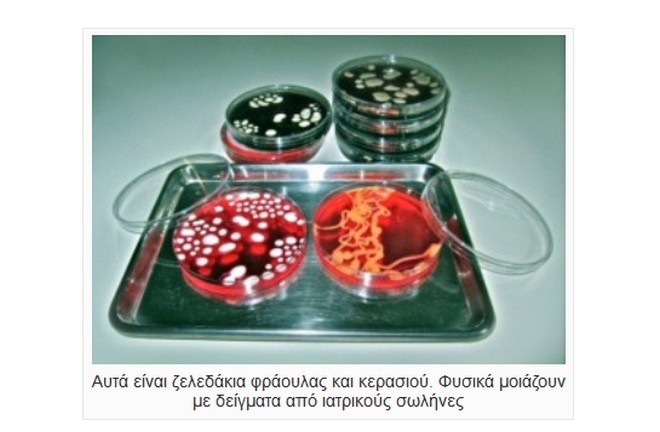

Φωτογραφίες-σοκ: “Αρρωστημένα” γλυκίσματα. Εσείς θα τα τρώγατε;

Νέα μόδα. Γλυκίσματα εμπνευσμένα από ασθένειες, που σοκάρουν (Pics)
- 23 Σεπτεμβρίου 2014 08:05
Tο NEWS247 σε συνεργασία με το InvitroMagazine σας παρουσιάζει μια νέα, αρρωστημένη μόδα.
Οι δημιουργοί γλυκών σε πολλά ζαχαροπλαστεία του εξωτερικού εμπνεύστηκαν από την ιατρική και αποφάσισαν να αποτυπώσουν την έμπνευση τους αυτή σε κουλουράκια, αμυγδαλωτά, κεικάκια και τούρτες.
Έτσι άρχισαν να φτιάχνουν αμυγδαλωτά σε σχήμα πιεσμένου στήθους την ώρα που γίνεται τομογραφία, εκλεράκια σε σχήμα σπερματοζωαρίων, τούρτες σε σχήμα μωρού την ώρα που βγαίνει μέσα από τη μητέρα του και άλλα.
Η εταιρία cake wrecks ήταν η πρώτη που ξεκίνησε να κατασκευάζει κέικς σε διάφορα σχήματα.
Δείτε τις φωτογραφίες
Διαβάστε ακόμα στο Invitromagazine:
7 περίεργα συμπτώματα, που κρύβουν σοβαρά προβλήματα υγείας
Δείτε ένα ζευγάρι να κάνει σεξ και να καταγράφεται από μαγνητικό τομογράφο